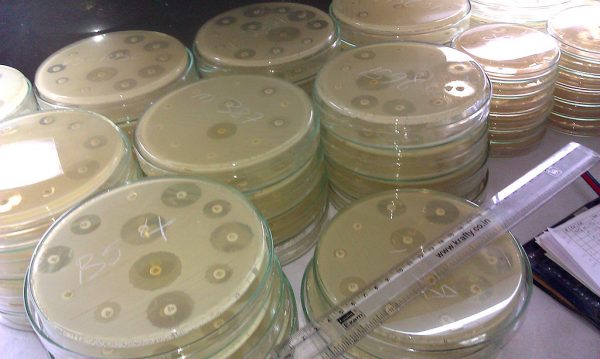

Welcome to this week’s Pandora Report! This issue features coverage of the Ebola outbreak in the Democratic Republic of Congo, updates on COVID-19 and long COVID, fallout from recent CDC leadership changes, highlights from new science communication books, and GMU alumni making an impact in public health and national security. Carmen Shaw, a first-year Biodefense PhD student also joined the Pandora Report this week as a co-managing editor. She will oversee the weekly newsletter.
Ebola in the DRC
Last week, Congo’s health authorities declared a new Ebola outbreak in Kasaï province, reporting 28 suspected cases and 15 deaths, including four health workers. WHO has confirmed this as the country’s 16th outbreak of Ebola since 1976, with a case fatality rate of roughly ≈54%. The index case – a 34-year-old pregnant woman admitted to the hospital last month – has died from multiple organ failure. In response, WHO has dispatched teams to strengthen surveillance, treatment and infection control. Yet local leaders warn that critical gaps remain. “The main challenges we face involve the lack of personnel and the shortage of personal protective equipment,” said Dr. Amitié Bukidi, head of the Mweka health zone. “Beyond that, our hospitals need to be supplied with medicines and special equipment capable of addressing this epidemic.”
Further Reading:
- “Ebola Outbreak in the DRC: Current Situation,” CDC
- “Congo’s Ebola outbreak can be contained if support increases, WHO official says,” Reuters
COVID-19 Trends, Vaccine Scrutiny, and Transparency Gaps in Response
COVID-19 activity in the U.S. continues to show signs of peaking, but the impact remains uneven. The CDC’s COVID-19 surveillance data reports that test positivity for SARS-CoV-2 has dipped to 10.8% from last week’s 11.6%, yet emergency visits rose slightly from 1.5% to 1.6% and remain elevated among children ages 0 – 4 and 5 – 17 years. Against this backdrop, the FDA Commissioner Marty Makary announced an “intense investigation” into anecdotal reports of childhood deaths following COVID-19 vaccination. While no causal link has been established and current evidence does not indicate major safety risks, the probe reflects heightened scrutiny of vaccine safety at a time when public confidence remains fragile.
Attention is shifting toward the global prevalence of long COVID, which the WHO defines as a “post-COVID-19 condition” involving lingering symptoms weeks or months after infection with COVID-19. A new global meta-analysis published in Open Forum Infectious Diseases found that many teens and adolescents reported long COVID, though most symptoms resolve within three months. In their analysis, the three strongest risk factors were being unvaccinated, infections from pre-Omicron variants, and female sex. The most frequently identified lingering symptoms were memory problems and muscle weakness. “Less than 30% of adolescents reporting symptoms who tested positive reported their symptoms persisted for three or more months,” the authors concluded.
Beyond the clinical challenges of COVID-19, concerns are mounting over U.S. transparency in infectious disease reporting and tracking. HHS has indefinitely suspended a CDC project that would have launched a real-time, user-friendly platform with case counts for 127 notifiable diseases, expert interpretation, and expanded surveillance data. Envisioned as a one-stop hub – akin to a “National Weather Service for public health” – the site was designed to centralize state-level reporting and eventually integrate emergency departments, mortality, and wastewater data. Its suspension follows leadership turmoil, including the recent firing of CDC Director Susan Monarez and the resignation of senior staff like Jennifer Layden [DK1] who led the agency’s Office of Public Health Data, Science, and Technology. “We lost a lot of staff, and we couldn’t re-hire,” Layden said, noting that the ability to be effective had become increasingly difficult. Scientists involved voiced frustration that after major gains in data integration and strategy, political interference and staffing cuts are eroding progress, leaving the U.S. less transparent and less prepared for future health threats.
Further Reading:
- “Mpox no longer international health emergency but remains concern in Africa,” Al Jazeera
- “‘We have basically destroyed what capacity we had to respond to a pandemic,’ says leading epidemiologist Michael Osterholm,” Nicoletta Lanese, Live Science
- “Global Prevalence of Long COVID, Its Subtypes, and Risk Factors: An Updated Systematic Review and Meta-analysis,” Hou et al., 2025
- “A long COVID researcher continues to search for answer,” Karen Feldscher, Harvard T.H. Chan SPH
Avian Influenza Updates
By Margeaux Malone, Pandora Report Associate Editor
Global Leaders Convene in Brazil to Address Escalating Bird Flu Threat
Approximately 500 experts from across the poultry industry, public health, science, and policy sectors met this week in Foz do Iguaçu, Brazil, for a global multisectoral dialogue on high pathogenicity avian influenza (HPAI). Organized by the Food and Agriculture Organization of the United Nations (FAO) in partnership with Brazil’s Ministry of Agriculture and Livestock, this landmark meeting aimed to coordinate international defense against the rapidly spreading highly pathogenic avian influenza (HPAI) H5N1 virus. Since 2020, HPAI has devastated poultry flocks globally and spread to 83 mammal species, including dairy cattle and wildlife. With far-reaching impacts on biodiversity, international trade, and global food security, the current avian influenza panzootic has prompted urgent calls for coordinated action.
The three-day summit focused on developing effective prevention and control strategies, building on the Global Strategy for the Prevention and Control of HPAI published by FAO in collaboration with the World Organization for Animal Health (WOAH) earlier this year. Key priorities included promoting early warning systems, vaccination strategies and biosecurity measures, with an emphasis on supporting vulnerable low-income countries and informal backyard poultry systems where surveillance and biosecurity remain challenging. Additionally, the summit focused on strengthening multisectoral coordination through a comprehensive One Health approach and sharing innovative and field-ready solutions for diagnostics, surveillance, and outbreak response. FAO Deputy Director-General Beth Bechdol stressed that “no single country or sector can tackle this threat in isolation, and failure is not an option. Practical, science-based collaboration like this is essential to protect our agrifood systems, livelihoods, and public health.”
The event marked the first time that government and scientific leaders were joined by private sector representatives in this type of global dialogue, allowing stakeholders to better understand industry challenges and also acknowledge the ongoing efforts and solutions being implemented by producers to combat the threat posed by H5N1.
Udderly Concerning: CDC Warns Raw Milk Could Carry H5N1 Risk
A new CDC report has concluded that the risk of potentially contracting H5N1 via ingestion of contaminated foods like raw milk and unpasteurized dairy products remains “low but theoretically possible”.
The CDC’s conclusion stemmed from analysis of scientific and medical literature demonstrating that influenza A may infect mammals through non-respiratory routes, including studies demonstrating that seasonal and novel flu viruses can spread to the GI tract of infected ferrets, reports of severe H5N1 infections in dogs and cats that consumed contaminated raw food or milk, and laboratory studies showing influenza A viruses can multiply in human GI tissues.
While it is unknown if avian influenza viruses can be transmitted to people through consumption of raw dairy products from infected cows, the agency emphasized that the possibility remains theoretically viable. Given that HPAI H5N1 has been found in commercially sold raw milk, CDC recommends avoiding the consumption of raw milk and unpasteurized dairy products, noting that pasteurization effectively inactivates influenza viruses. Officials also urge proper cooking of poultry, eggs, and beef to appropriate internal temperatures.
Further Reading:
- “Scientists Begin Testing Bird Flu Vaccine in Seals,” Emily Anthes, The New York Times
- “Cat in San Francisco euthanized after latest bird flu infection tied to raw pet food,” Jonel Aleccia, Associated Press
- “Earlier H5N1 detection adds to Texas dairy herd total; researchers can’t pinpoint source of California child’s illness,” Lisa Schnirring, CIDRAP
- “Bird flu fears spark demand for stricter shoot rules,” Steffan Messenger, BBC
Policy & Public Health Leadership
The turmoil at the CDC continues to reverberate. Last Thursday, Secretary Robert F. Kennedy Jr. appeared before the Senate Finance Committee in a hearing that quickly turned contentious. Lawmakers from both parties pressed him on his decision to fire CDC Director Susan Monarez, appoint vocal vaccine skeptics to the advisory panel that guides immunization policy, and narrow access to updated COVID-19 vaccines. At several points, Secretary Kennedy contradicted established evidence – from vaccine safety and effectiveness to estimates of how many lives COVID-19 vaccines have saved.
Despite Secretary Kennedy’s assurances to lawmakers that “anyone” could get a COVID-19 vaccine, many Americans have reported difficulty accessing updated shots due to patchy pharmacy supply, shifting eligibility rules, and state-level confusion. Doctors, pharmacists, and local health officials are scrambling to adapt while the Advisory Committee on Immunization Practices prepares to meet on September 18 to set national guidance. In the meantime, this confusion has left vulnerable populations at risk, pending clearer guidance.
In the days following the hearing, the fallout was swift. Several members of Secretary Kennedy’s own family, including Joseph P. Kennedy III and Kerry Kennedy, publicly called for his resignation, warning that his leadership poses a direct threat to Americans’ health and wellbeing. Their criticism added to bipartisan concern in Congress and growing unease among state and local officials tasked with implementing vaccine policy. Looking ahead, the spotlight will turn back to the CDC on September 17, when former director Susan Monarez is set to testify before a Senate panel about her dismissal and the wave of high-profile resignations that followed.
Further Reading:
- “I resigned from the CDC. Here are three questions for RFK Jr.,” Debra Houry, Washington Post
- “Robert F. Kennedy Jr., the CDC and Me,” Susan Monarez, Wall Street Journal
- “How to get a coronavirus vaccine and who’s eligible amid limited access,” David Ovalle, Washington Post
- “Doubts about RFK Jr. grow for some Republicans,” Dan Diamond, Theodoric Meyer, and Rachel Roubein, Washington Post
- “Surgeons general warning: CDC saves lives. It’s up to us to save public health,” Joycelyn Elders, USA Today
George Mason University Alumni Spotlight
Scott Wollek, MPA ’12 and adjunct professor in the Biodefense Graduate Program at the Schar School of Policy and Government has been named the new Director of the Maryland Hospital Preparedness Program (HPP) at the Maryland Hospital Association (MHA).

Scott, a recognized expert in public health and healthcare emergency preparedness and health security, brings policy experience from leading a health emergency preparedness portfolio at the National Academies of Sciences, Engineering and Medicine, including collaborations with ASPR, NIH, DHS and SLTT health departments and private/non-profit healthcare systems, as well practical, operational experience in emergency response and capacity building from service with American Red Cross Disaster Services in the National Capital Region to his new role.
Now in its third decade, the HPP program provides regional collaboration statewide for health care system readiness. In Maryland the program is implemented through partnership between the Maryland Department of Health and MHA. HPP supports four regional healthcare coalitions across Maryland, bringing together hospitals, EMS, emergency management, and local health departments to strengthen and build capacity for response to disasters and large-scale emergencies.
Craig Wiener, PhD ‘16 in Biodefense (Concentration in International Security) at the Schar School of Policy and Government has been appointed as a Nonresident Fellow in Science and Technology Policy and Research Security at Rice University’s Baker Institute for Public Policy.

The Baker Institute is consistently ranked among the world’s top university-based think tanks, known for its nonpartisan, policy-relevant research on global and domestic challenges—from energy, trade, and diplomacy to science, technology, and security.
Wiener said, “In this capacity, I look forward to contributing to the Institute’s Science & Technology Policy Program, with a special focus on safeguarding research integrity and driving forward-thinking policy at the nexus of science, technology, and national security. This new role is complementary to my principal responsibilities as a Technical Fellow at MITRE, advising the U.S. Government, the Department of Defense, and the Intelligence Community on cybersecurity, CBRN defense, and national-level threat analysis. I will continue as a Fellow at George Mason University’s National Security Institute, at the Antonin Scalia Law School, where I engage on security issues with a nexus to U.S. national security law, defense and intelligence.”
“At the Baker Institute, I aim to help shape policy-relevant research that reinforces U.S. leadership in secure science and technology innovation, addresses the strategic dimensions of emerging technologies, and supports evidence-based decision-making.”
“I am grateful for this opportunity—and excited to collaborate with the renowned team at the Science & Technology Policy Program, alongside the broader community at Rice University and beyond.”

How to Be an Ambassador for Science: The Scientist as Public Intellectual by James L. Olds
How to be a Science Ambassador by James L. Olds explores what it means for scientists to step beyond the lab and act as public intellectuals. Drawing on decades of experience in Washington, D.C., and abroad, Olds offers practical guidance on navigating the science-policy ecosystem, engaging in diplomacy and managing crises. He emphasizes the importance of building coalitions, forging trust across political divides, and learning how to advocate effectively for science with leaders and the public. Designed as a “how-to” guide, the book provides students and professionals alike with tools to strengthen their science communication skills and embrace leadership roles in the broader public arena.
In The Big One, Michael T. Osterholm and Mark Olshaker warn that while COVID-19 was devastating, it was not the catastrophic pandemic experts fear most. Drawing on history, they analyze how societies have confronted past pandemics, evaluate the global response to COVID-19, and project scenarios for future outbreaks. The book underscores that the world already has many of the tools needed to prepare – from rapid vaccine platforms to stronger public health systems – but political will and sustained investment remain lacking. Framed as both a cautionary tale and a practical guide, The Big One argues that readiness today is the only way to prevent disaster tomorrow.

CTD–SPECTRE Symposium, “Tropical and Emerging Infectious Diseases for Clinicians and Translational Scientists”
“The CTD-SPECTRE Symposium on Tropical and Emerging Infectious Diseases for Clinicians and Translational Scientists 2025 offers a unique opportunity to connect with global experts, gain cutting-edge insights, and collaborate with peers dedicated to infectious disease research and treatment.”
“Taking place September 16 -19, 2025, at the historic Grand Galvez in Galveston, TX, this immersive symposium will unite clinicians, translational investigators, and trainees to explore the latest breakthroughs in tropical and emerging infectious diseases.”
“Hosted by the Division of Infectious Diseases at UTMB, Center for Tropical Diseases (CTD) and Special Pathogens Excellence in Clinical Treatment, Readiness, & Education (SPECTRE) Program.”
Learn more and register here.
Mirror Image Biology: Pushing the Envelope in Designing Biological Systems – A Workshop
From NASEM: “Most biological molecules are chiral entities where their mirror images have different structures and functional characteristics. Scientists have begun synthesizing left-handed DNA and RNA and creating proteins that can write left-handed nucleic acids. This, and other related research, is described as “mirror biology” and includes research toward creating mirror-image self-replicating living systems. The National Academies will host a foundational workshop on mirror biology, focusing on the state of the science, trends in research and development, risks and benefits of this research, and considerations relating for future governance of relevant enabling technologies.”
This event will take place virtually, September 29-30. Register here.
Doing More with Less: Practical Biosafety on a Budget
“Led by Azelia Labs biosafety experts, Katerina Semenyuk, PhD, RBP (ABSA) and Sarah Ziegler, PhD, RPB, CBSP (ABSA) this webinar will provide a comprehensive guide to maintaining a robust biosafety program in resource-constrained environments. We will address the unique challenges that arise when faced with limited funding or leadership hesitation to invest in safety protocols.”
“This session will focus on practical, actionable strategies to overcome these obstacles. Topics will include how to prioritize essential safety measures when budgets are tight, creative solutions for providing adequate personal protective equipment (PPE), and innovative approaches to maintaining equipment and facilities without costly upgrades. We will also discuss methods for effectively communicating the value of biosafety to leadership to secure the necessary support for your program.”
This online event will take place on October 2, 12-1 pm EDT. Register here.
EMBRACE 2025 – Scientific Pathways to Biotoxin Preparedness Online Event
From CMINE: “Join us at the forefront of chemical and biological security for EMBRACE 2025 – a key event dedicated to cutting-edge research on biotoxins and human biomarkers of intoxication. This international symposium will spotlight ground-breaking scientific work and host the inauguration of EMBRACE’s Biotoxin Task Force.”
“What to Expect:
A unique opportunity to shape the scientific landscape of biotoxin threat preparedness and learn more about the EU EMBRACE project and the Biotoxin Task Force
A platform for showcasing innovation in biotoxin detection and response
Networking with global experts in biological forensics and toxicology”
This event will take place on October 15, 0900-1700 CEST. Register here.
Global Conference on Biological Threat Reduction
From the World Organisation for Animal Health: “In October 2025, WOAH is hosting its third Global Conference, with the goal of galvanising advocacy efforts to manage the rising risk of biological threats from across the world.”
“The Global Conference on Biological Threat Reduction – which will take place in Geneva on 28-30 October 2025 – will bring together top minds in the fields of
health-security, emerging technologies, and biothreat reduction policies, from the public and private sectors – to focus on the latest strategies, challenges and innovations in combating biological threats to our interconnected ecosystems.”
“The Conference will bring together approximately 400 participants from different sectors, including animal health, law enforcement and security, public health, international and regional organisations, investment and development partners, private sector and industry representatives, research, academia and regulatory authorities, youth organisations.”
“Attendees will engage in thought-provoking discussions and innovative technical presentations aimed at strengthening prevention, preparedness and response capabilities across the world.”
“The event will be guided by a narrative that traces WOAH’s commitment to biological threat reduction and the increasingly relevant role it plays at the health-security interface. Against the backdrop of an uncertain future, WOAH believes that synergies between sectors can drive positive change – making the world a safer and healthier place. ”
Learn more and register here.
GHS 2026
From GHS: “We’re excited to officially announce that the 4th Global Health Security Conference (GHS2026) will be held in Kuala Lumpur on the 9 – 12 June, 2026!”
“Building on the incredible momentum of GHS2024 in Sydney, we look forward to bringing together the global health security community once again – this time in one of Southeast Asia’s most vibrant and dynamic cities.”
“Registration and Call for Abstracts are now live!”
Learn more, submit abstracts, and register here.

Applied Biosafety Call for Papers
“The Editors of Applied Biosafety are pleased to announce a forthcoming Special Issue focused on the myriad of topics associated with global biosafety management. This special issue will showcase examples of innovative approaches, creative solutions, and best practices developed and used around the world for managing risks associated with the handling, use, and storage of infectious biological agents, toxins, and potentially infectious materials in research and clinical settings.”
Learn more and submit by November 1 here.
64th ISODARCO Course
From ISODARCO: “In recent years, the global security landscape has become increasingly volatile, shaped by a convergence of geopolitical tensions, technological advancements, and evolving nuclear doctrines. The post-Cold War order that once provided a measure of predictability in global security has eroded. Conflicts such as the wars in Ukraine and Gaza, rising tensions in the Indo-Pacific, and strategic competition between major powers have reshaped alliances and strategic postures.”
“At the same time, disruptive technologies including artificial intelligence, quantum computing, hypersonic missiles, and cyber threats – are adding new layers of complexity to both nuclear and conventional deterrence dynamics. These technologies are not only distorting the information landscape but also compressing decision-making timelines and complicating signaling mechanisms, increasing the risk of miscalculation.”
“Effectively managing nuclear escalation risks in this environment will require a combination of innovative diplomacy, technological safeguards, and renewed dialogue mechanisms to rebuild trust, reduce misperceptions, and stabilize strategic relations.”
“The ISODARCO 2026 Winter Course presents an invaluable opportunity for students and experts to discuss and examine these dynamics in depth and explore approaches to re-establishing strategic stability and reducing nuclear dangers in a volatile world.”
This course will take place January 11-18, 2026, in Andalo. Learn more and apply here.

GMU Biodefense Director Talks Growing Threats and Lack of Action
GMU Biodefense Director Talks Growing Threats and Lack of Action